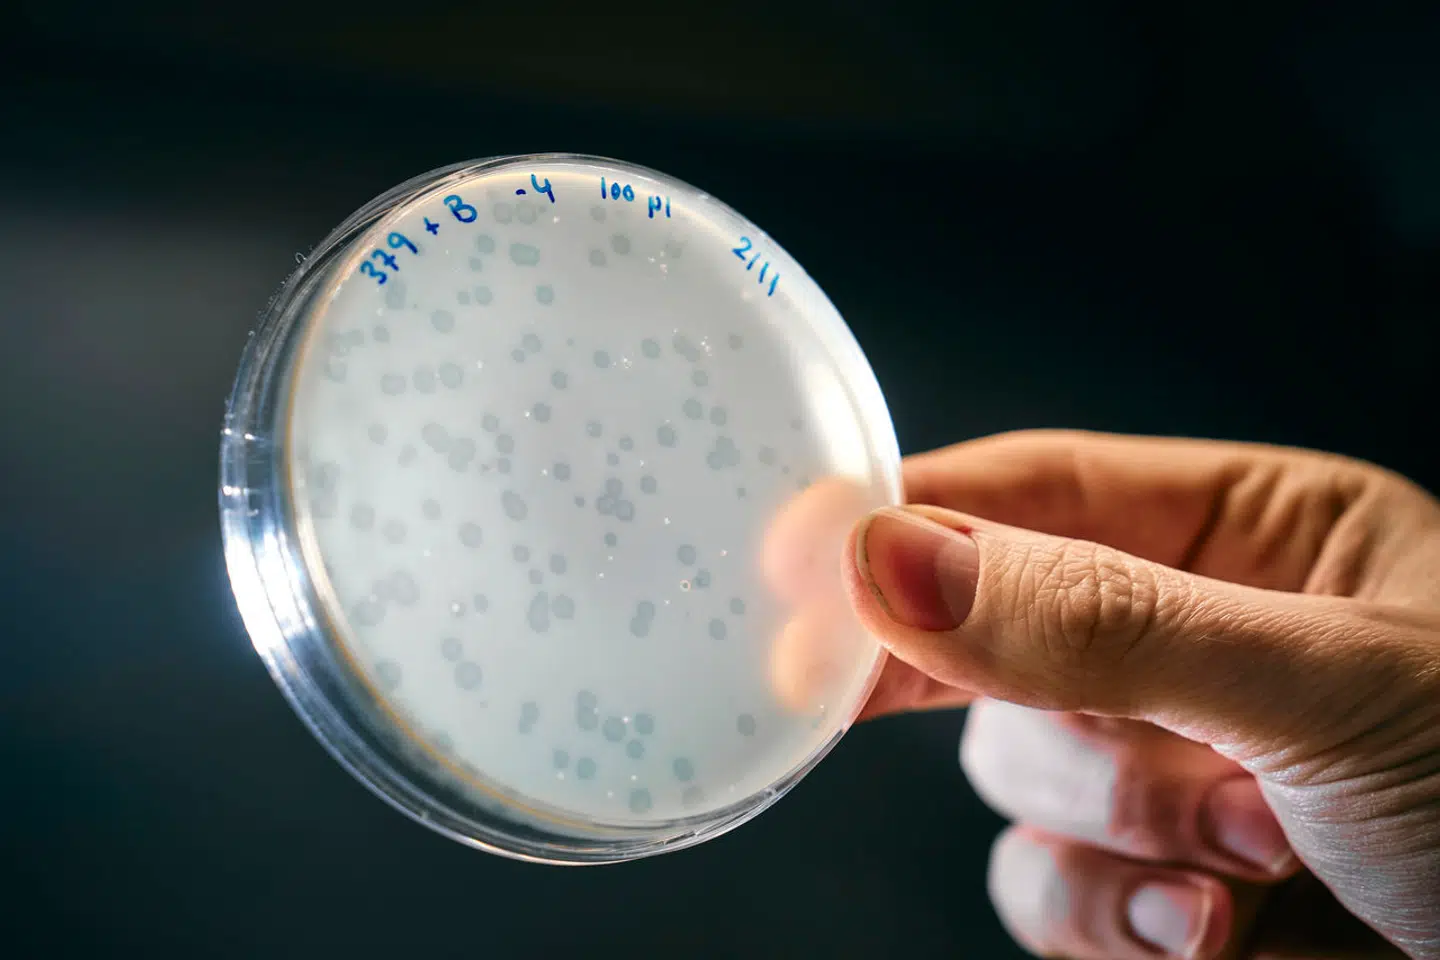

På dette tidspunkt af året er det normalt, at landmænd er ude at køre om natten for at nå i mål med såningen af afgrøderne til den næste høst.
Men natten til lørdag ville deres traktorer pludselig ikke køre.
Den kraftige solstorm, som mellem fredag og lørdag gjorde det muligt at se nordlyset på himlen, slog nemlig samtidig flere landbrugsmaskiner ud af drift. Det skriver mediet ING.
Årsagen til, at traktorer uden varsel holdt op med at virke natten til lørdag, er, at mange traktorer er udstyret med et navigationsudstyr ved navn RKT.
RKT er en type GPS-system, der foretager meget præcise målinger af jord i realtid. Målingerne sendes ud til kørende traktorer, sådan så landmænd kan lade styringen af traktoren være op til RKT-tjenesten, mens de ser til marken.
Men tjenesten virker kun, hvis ikke signalet forstyrres – for eksempel af en solstorm, som frigiver enorme mængder magnetisk energi fra solen og rammer satellitter på sin vej gennem i ionosfæren.
Det er før sket, at satellitter er blevet slået ud af kurs af de elektromagnetiske stråler fra en solstorm, og af den grund er satellitproducenter også begyndt at udvikle mere robuste satellitter. Derfor er det også særligt ældre RKT-systemer, som blev ramt af weekendens solstorm.
Til ING fortæller Niels Rasmussen, formand for brancheforeningen for private referencenet og direktør i Geoteam, der driver RTK-netværket Gpsnet.dk, at op mod 10 procent af de landmænd, der har kørt natten til lørdag med RTK, har været påvirket af solstormen.
Også i andre dele af verden har man oplevet, at traktorerne stod af natten til lørdag.
I The New York Times fortæller flere amerikanske landmænd, hvordan de fik sved på panden, da forstyrrende satellitsignaler fik deres traktorer til lige pludselig at gå i stå.